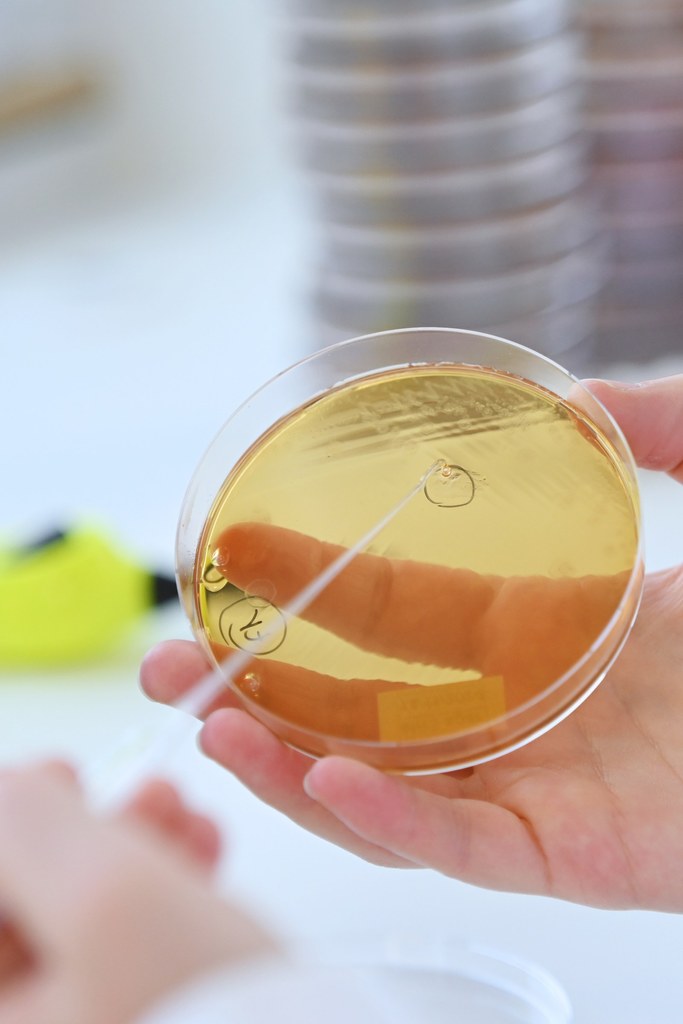

Skin Microbiome: Cultivating Rigor to Objectify Innovation
The skin microbiome is not mere scenery. It is a functional component of the skin, involved in protection against pathogens, immune dialogue, and the modulation of inflammation. It is a dynamic ecosystem shaped by subtle interactions between bacteria, yeasts, the host, and the environment.
Smaltis is an independent microbiology laboratory specializing in the design and execution of tailor-made studies for the healthcare and cosmetics sectors.
Our approach is grounded in a simple conviction: understanding a microbiome is not merely about identifying it. It is about knowing how to culture it, interrogate it, and generate scientifically defensible data.
This is precisely how we approach the skin microbiome: as a complex ecosystem whose actors, dynamics, and mechanisms must be mastered before attempting to modulate its balance.
Cutaneous Dysbiosis: Moving Beyond Mere Presence
In acne, atopic dermatitis, or seborrheic dermatitis, the key question is rarely “who is present?” but rather “what has shifted in the local balance?”
Dysbiosis rarely reflects simple presence or absence. It typically results from subtle imbalances between species, strains, or phylotypes, influenced by the cutaneous context: sebum, pH, moisture, barrier integrity, and environmental exposure.
Thinking as microbiologists therefore means targeting the relevant microorganisms, selecting the appropriate level of complexity, and defining readouts consistent with the underlying hypothesis.
A sound study always begins with a sound question. But appropriate models are essential to answer it.

Cultivating the Invisible: Making the Microbiome Testable
Working on the skin microbiome relies on a core expertise: knowing how to culture the right strains under the right conditions. Without this, results may lack representativeness or reproducibility.
Take Malassezia restricta, a lipophilic yeast of the scalp implicated in seborrheic dermatitis: specific lipid requirements, slow growth, controlled atmospheric conditions. What may appear “standard” in a protocol can become a genuine experimental challenge.
The same applies to Cutibacterium acnes: its seven phylotypes do not have the same impact in acne. Incorporating phylogenetic distinctions significantly strengthens the scientific relevance of both testing and interpretation.
Depending on the indication, we also integrate other key species such as Staphylococcus aureus, involved in atopic dermatitis, or Candida albicans, studied either individually or in interaction models when this provides additional ecological relevance.
From Screening to Mechanistic Studies: Structuring the Evidence
Objectives vary: to explore, compare, understand, or consolidate evidence. The challenge is to answer meaningful questions regarding selectivity, robustness, context, and mechanism.
We support our partners from strain-panel screening to readouts capable of distinguishing static effects (bacteriostatic/fungistatic) from cidal effects (bactericidal/fungicidal), and of linking a phenotype to a defensible mechanistic hypothesis (membrane targeting, biosynthesis pathways, metabolism, functional signatures).
After screening or an initial mechanistic readout comes the decisive step: transforming an experimental signal into actionable evidence. Moving from “it works” to “it works in which context, against which microorganisms, with what level of selectivity, and why.”
For example, in Malassezia, certain compounds combine an “ergosterol signature” with metabolic impact, suggesting a potentially hybrid mechanism of action. In Cutibacterium acnes, reasoning at the phylotype level allows evaluation of both efficacy and selectivity considering profiles associated with inflammation or skin homeostasis.
This structured approach not only objectifies an observed effect but also strengthens the scientific dossier and anticipates the credibility of microbiome-related claims.
The Smaltis Two-Step Approach
Strategy depends on project maturity.
When the scientific question needs to be built or clarified, our Research Microbiology unit co-designs the study plan: strain selection, complexity level, evaluation criteria.
When methodologies are established, Precision Microbiology ensures robust, reproducible, and comparable execution.

From the Laboratory to the Volunteer: Connecting Mechanisms to Reality
Once in vitro models are consolidated, the next step is to verify whether observations hold true within the reality of a living, variable, and context-dependent microbiome.
Smaltis can rely on studies including healthy volunteers and skin sampling to contextualize findings, stratify microbiome profiles, and measure impact in a more ecological manner through relevant microbiological markers.
Supporting Innovation with Scientific Rigor
The skin microbiome field is expanding rapidly, while simultaneously undergoing scientific and regulatory structuring.
In this context, microbiological rigor becomes a differentiating factor:
asking the right question, choosing the right model, mastering demanding cultures, linking effects to mechanisms, and confronting results with the real ecosystem.
At Smaltis, we transform microbiological hypotheses into solid, actionable, and credible data.
Because before speaking about microbiomes, one must first speak the language of microbiology.
CONTACT
MENEGHEL Clarisse – Business contact
clarisse.meneghel@smaltis.com






